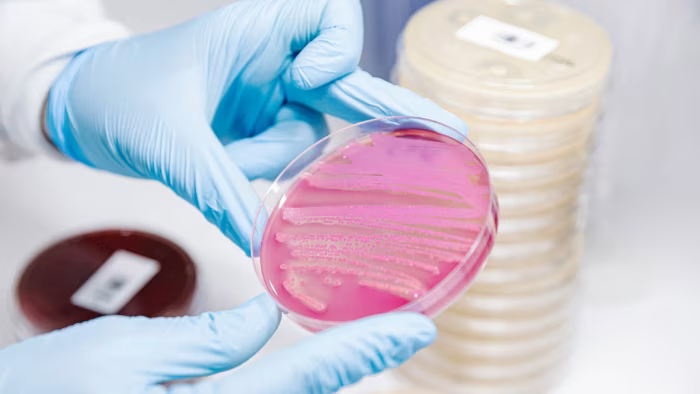

AI shpallet Njeriu i Vitit nga TIME
Personazhet që po e projektojnë këtë arkitekturë, me të gjitha fuqitë dhe rreziqet që sjellin, janë Personi i Vitit sipas TIMEMë të lexuarat
SIPRI zbulon numrin e dronëve kamikazë që ka marrë Shqipëria
Irani, testi i madh për doktrinën amerikane të luftës — dhe mësimi nga Kosova
2Thjesht mos e thuaj fjalën që fillon me “L”
3Forbes: Samir Mane shton 400 mln dollarë pasuri, ngjitet në 1.9 miliardë
4“2025-ta vit i humbur”: Çfarë thotë raporti i Terras për Kosovën?
5Përzgjedhur nga redaksia
Parlamenti nuk është noter i arrestimeve
AI hap një kapitull të ri në krijimin e antibiotikëve kundër baktereve rezistente
Inteligjenca artificiale po ndihmon në zhvillimin e antibiotikëve të rinj për të luftuar baktere rezistente.Ilustrim
Alketa Rama
11.12.2025 15:26Më të lexuarat
SIPRI zbulon numrin e dronëve kamikazë që ka marrë Shqipëria
Irani, testi i madh për doktrinën amerikane të luftës — dhe mësimi nga Kosova
2Thjesht mos e thuaj fjalën që fillon me “L”
3Forbes: Samir Mane shton 400 mln dollarë pasuri, ngjitet në 1.9 miliardë
4“2025-ta vit i humbur”: Çfarë thotë raporti i Terras për Kosovën?
5Përzgjedhur nga redaksia
Parlamenti nuk është noter i arrestimeve
Si po ndryshon Agentic AI zbulimin dhe blerjen e produkteve të bukurisë?
Agentic AI po transformon zbulimin dhe blerjen e produkteve të bukurisë, duke vepruar si një asistent personal autonom që sugjeron, krahaso dhe blen për përdoruesit.Më të lexuarat
SIPRI zbulon numrin e dronëve kamikazë që ka marrë Shqipëria
Irani, testi i madh për doktrinën amerikane të luftës — dhe mësimi nga Kosova
2Thjesht mos e thuaj fjalën që fillon me “L”
3Forbes: Samir Mane shton 400 mln dollarë pasuri, ngjitet në 1.9 miliardë
4“2025-ta vit i humbur”: Çfarë thotë raporti i Terras për Kosovën?
5